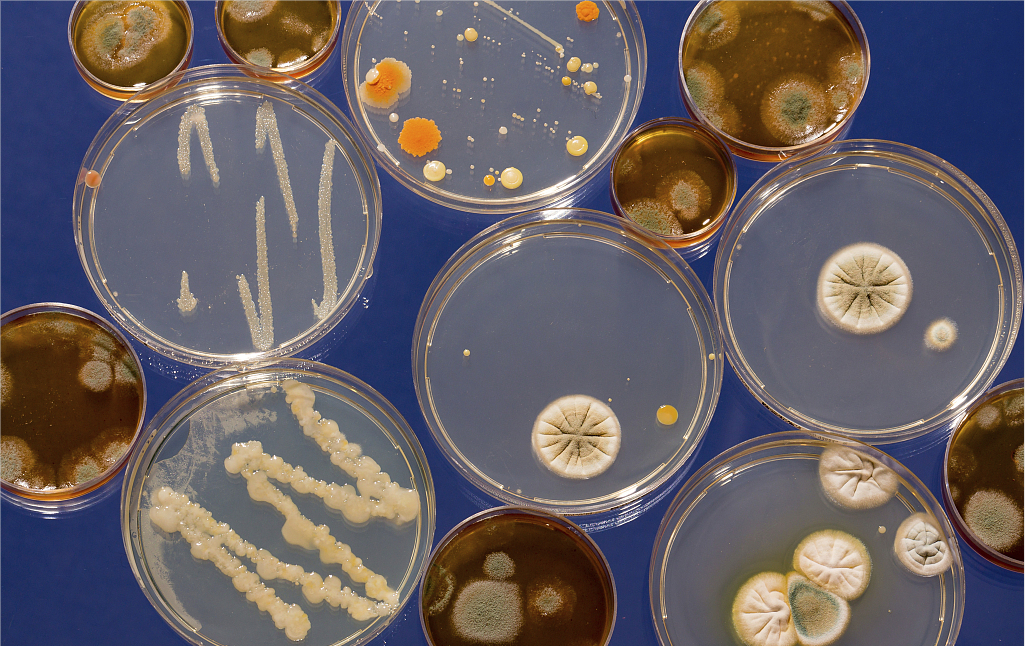

微生物·菌类检测
微生物检测介绍:细菌、病毒、真菌以及一些小型的原生生物、显微藻类等在内的一大类生物群体,它个体微小,与人类关系密切。涵盖了有益跟有害的众多种类,广泛涉及食品、医药、工农业、环保等诸多领域。微生物是衡量产品质量是否安全的一项重要指标,微生物超出一定限值,不但会使产品变质、失去应用的价值,而且会影响人类健康。
一、微生物检测
对样品中的微生物数量进行检测。
检测项目包括:菌落总数、大肠菌群、霉菌、酵母菌、金黄色葡萄球菌、沙门氏菌、志贺氏菌、细菌总数、真菌总数、绿脓杆菌、溶血性链球菌、白色念珠菌、单增李斯特氏菌、副溶血性弧菌、乳酸菌、芽孢杆菌、双歧杆菌、地衣芽孢杆菌、铁细菌、硫酸盐还原菌、肉毒杆菌、光合细菌、放线菌、粪链球菌、嗜酸乳杆菌、嗜热链球菌、干酪乳杆菌、沼泽红假单胞菌等。
【检测样品】:各类食品、保健品、药品、饲料、肥料、土壤、水质、化妆品、日化用品、一次性卫生用品等。
二、抑菌/杀菌效果评价
抑菌/杀菌效果评价是针对于抑制/杀灭某种菌进行的试验,因此,实验时需指明抑制/杀灭的具体菌种。
如对大肠杆菌、金黄色葡萄球菌、白色念珠菌、绿脓杆菌等抑菌/杀菌效果的评价。
【检测样品】:各种具有抑菌/杀菌效果的日化产品、化妆品、纺织品、抑菌/杀菌剂、橡胶、塑料、功能性材料等。
三、抗菌效果评价
抗菌效果评价是针对于抗某种菌进行的试验,因此,实验时需指明抗菌的具体菌种。
如对大肠杆菌、金黄色葡萄球菌、白色念珠菌、绿脓杆菌等抗菌效果的评价。
【检测样品】:各种具有抗菌效果的日化产品、化妆品、纺织品、抗菌剂、家具、涂料、抗菌材料、橡胶、塑料、功能性材料等。
四、防霉等级评定
对样品进行防霉实验,最终对样品进行防霉等级的评定。一般霉菌种类较多,检测可依据标准中指定的霉菌种类进行防霉实验,也可根据检测产品选用霉菌种类。
纺织品防霉实验常用的霉菌有:黑曲霉、球毛壳霉、绳状青霉、绿色木霉
塑料防霉实验常用的霉菌有:黑曲霉、球毛壳霉、绳状青霉、绿粘帚霉、出芽短梗霉
橡胶防霉实验常用的霉菌有:黑曲霉、球毛壳霉、绳状青霉、帚霉、出芽短梗霉
皮革防霉实验常用的霉菌有:黄曲霉、黑曲霉、大毛霉、产黄青霉、桔灰青霉、变幻青霉、马氏拟青霉、绿色木霉
【检测样品】:各种具有防霉效果的橡胶、塑料、皮革、纺织品、木板、功能性材料等。
五、防螨/杀螨实验
对样品进行防螨/杀螨实验。
【检测样品】:各种纺织品、杀螨剂等。
六、商业无菌(无菌检测)
对罐装产品、瓶装产品,进行的无菌检测,即商业无菌检测。
【检测样品】:各种罐头、瓶装产品等。
七、菌种鉴定
对未知的细菌、真菌进行鉴定。
八、生物降解试验
生物降解度测试


 客服电话:
客服电话: